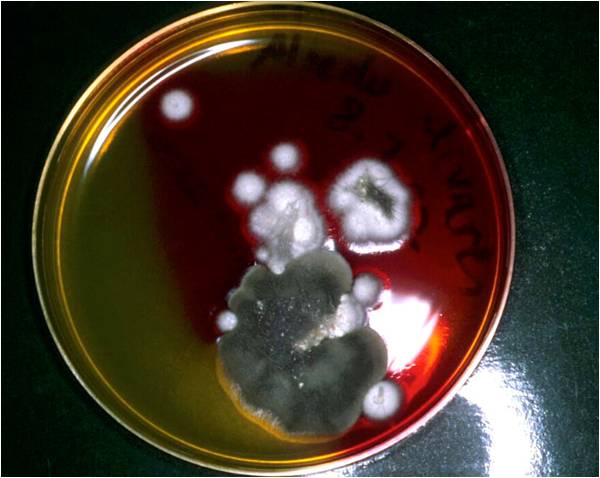

Figura 3

Figura 4

Figura 5
1. Raspados cutáneos
2. Prueba de la cinta adhesiva
3. Tricograma
4. Cultivo fúngico (DTM)
En los raspados cutáneos se evidencia un ácaro (Figura 3). Después de siete días el resultado del cultivo DTM es positivo: ha crecido una colonia de aspecto blanquecino y algodonoso provocando el viraje de color del medio (Figura 4). Al hacer una impronta con celo de la colonia y teñirla, se observa los órganos de fructificación del hongo (Figura 5).

Figura 3 |
Figura 4 |

Figura 5 |